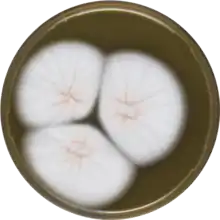

Aspergillus sulphureus
Aspergillus sulphureus is a species of fungus belonging to the family Aspergillaceae.[1]
| Aspergillus sulphureus | |
|---|---|
![]() | |
| Scientific classification | |
| Kingdom: | Fungi |
| Division: | Ascomycota |
| Class: | Eurotiomycetes |
| Order: | Eurotiales |
| Family: | Trichocomaceae |
| Genus: | Aspergillus |
| Species: | A. sulphureus |
| Binomial name | |
| Aspergillus sulphureus (Fresen.) Thom & Church, 1926 | |
References
- "Index Fungorum - Names Record". www.indexfungorum.org. Retrieved 27 January 2021.
This article is issued from Wikipedia. The text is licensed under Creative Commons - Attribution - Sharealike. Additional terms may apply for the media files.